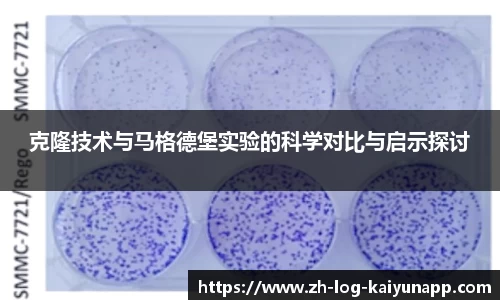
关键词4

克隆技术与马格德堡实验的科学对比与启示探讨
本文旨在探讨克隆技术与马格德堡实验之间的科学对比与启示。首先,从历史背景和科学原理出发,分析这两个领域所涉及的基本概念及其发展历程。其次,关注它们在科学研究方法上的不同,通过具体案例展示各自的优势与局限性。此外,将讨论二者对当代科技进步及伦理思考的影响,特别是在生命科学领域中的应用和争议。最后,结合两者的比较,总结出其对未来科学发展的重要启示,为进一步的研究提供参考。
1、克隆技术的发展历程
克隆技术作为现代生物学的重要组成部分,其发展经历了多个阶段。从最早的细胞分裂研究到1996年“多莉羊”的成功克隆,这项技术不断推动着生物学和医学的发展。在此过程中,科学家们逐渐掌握了细胞核移植、基因编辑等核心技术,使得克隆不仅限于动物,更扩展到了植物和微生物等领域。
而随着科技的不断进步,克隆技术也面临着越来越多的伦理问题。例如,关于人类克隆是否应被允许的问题引发了广泛讨论。这些讨论不仅涉及到法律层面的规范,也关系到道德、社会认同等更深层次的问题。因此,在推进科技发展的同时,对其潜在风险进行评估显得尤为重要。
此外,克隆技术在医学上的应用也为疾病治疗带来了新的希望。通过个体化医疗和干细胞研究,科学家可以利用克隆技术生成特定类型的细胞或组织,以帮助修复损伤或治疗遗传病。这一切都表明,尽管克隆技术具有诸多挑战,但其潜力不可小觑。
2、马格德堡实验的历史意义
马格德堡实验是17世纪德国物理学家盖里科(Gottfried Wilhelm Leibniz)进行的一项经典实验,该实验通过创造真空来探讨气压现象。这一实验不仅奠定了气体动力学基础,还揭示了大气压力的重要性,对后来的物理学发展产生了深远影响。
尽管马格德堡实验相较于现代科学技术较为简单,但它所采用的方法论值得我们深入思考。该实验强调实证观察与理论推导的重要性,这种严谨求证的方法至今仍是科学研究中不可或缺的一部分。同时,它还激励着后续科研人员探索未知世界,对于促进自然科学的发展起到了积极作用。
此外,马格德堡实验使人们意识到自然界中的各种力量,如压力、重力等,不仅存在于宏观世界,同样影响微观事物。这一思想为后来的许多理论打下了基础,例如热力学、流体力学等领域均受益于此,因此,其历史意义不容忽视。
3、两者方法论的比较
在人类探索未知领域时,不同的方法论往往导致截然不同的结果。克隆技术主要依靠先进的生物工程手段,通过操作基因组实现复制,而马格德堡实验则强调通过观察和实践来获取知识。这两种方法在本质上反映出了不同类型科研工作的特点:前者体现的是现代科技迅猛发展的时代特征,而后者则代表早期自然哲学向现代科学转变过程中的一种探索方式。
从数据获取角度看,克隆过程通常依赖大量精密仪器及高端设备,而马格德堡实验则更注重简洁明晰、易于重复验证的方法。这种差异使得前者可能会导致一些复杂的问题,如伦理争议,而后者则因其实验相对简单而被广泛接受。因此,两者在实际应用中可谓各有优劣,各自承载着不同历史时期人类认知能力的发展历程。
总之,两种方法论之间既有联系又有区别,需要我们根据具体问题选择合适的方法。在某些情况下,可以尝试将二者结合,以期达到更加全面深入的理解,从而推动相关领域的发展。
4、对未来科技发展的启示
从克隆技术与马格德堡实验中,我们可以得到一些关于未来科技发展的启示。首先,要重视基础研究的重要性,无论是复杂的新兴科技还是传统自然现象,都需要扎实可靠的数据支持。而这一点正是马格德堡实验给我们的警示,即没有足够的数据支撑,再先进的理论也无法立足。
其次,在推动新兴科技进步时,要保持对伦理问题的高度敏感。尤其是在生物工程领域,例如人类胚胎干细胞研究以及基因编辑等,一旦触碰伦理底线,将会引发社会的不安甚至抵制。因此,需要建立健全相关法规,并鼓励公众参与讨论,共同设定道德标准。
最后,我们应该鼓励跨学科合作,不同领域间交叉合作能够产生意想不到的新思路。例如,在生物医学与人工智能结合方面,新兴工具将极大提升疾病诊断水平,这无疑是一种借鉴传统经验并融合现代科技创新的大趋势。
总结:
综上所述,克隆技术与马格德堡实验虽然处于不同历史背景下,却都承载着丰富的人类智慧与探索精神。在比较二者时,我们不仅要看到它们各自的发展历程和方法论,还应关注它们在当代社会中的意义和价值。未来,我们需要吸取这些经验教训,以更好地面对日益复杂多变的科学挑战,从而实现可持续发展目标。
最后,无论是继续深化对生命奥秘的探索还是解决当今社会面临的问题,都离不开扎实的基础研究和开放包容的态度。在这样的理念指导下,人类必将在不断追求真理中开创更加美好的未来。






